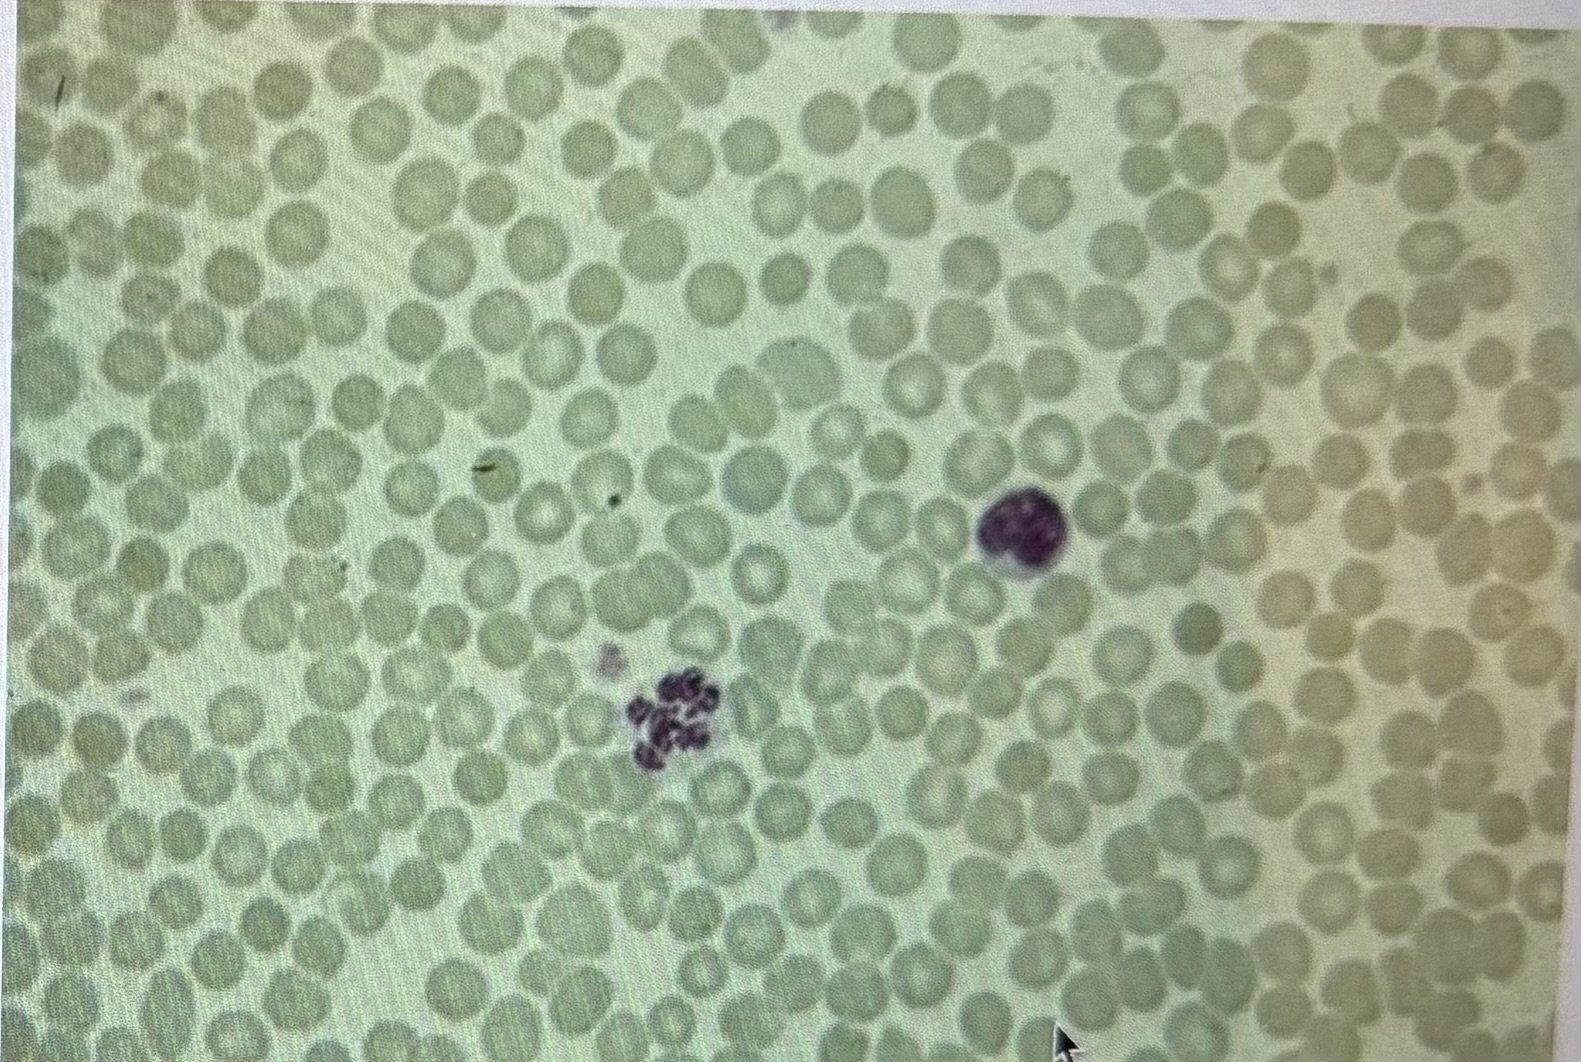
term image
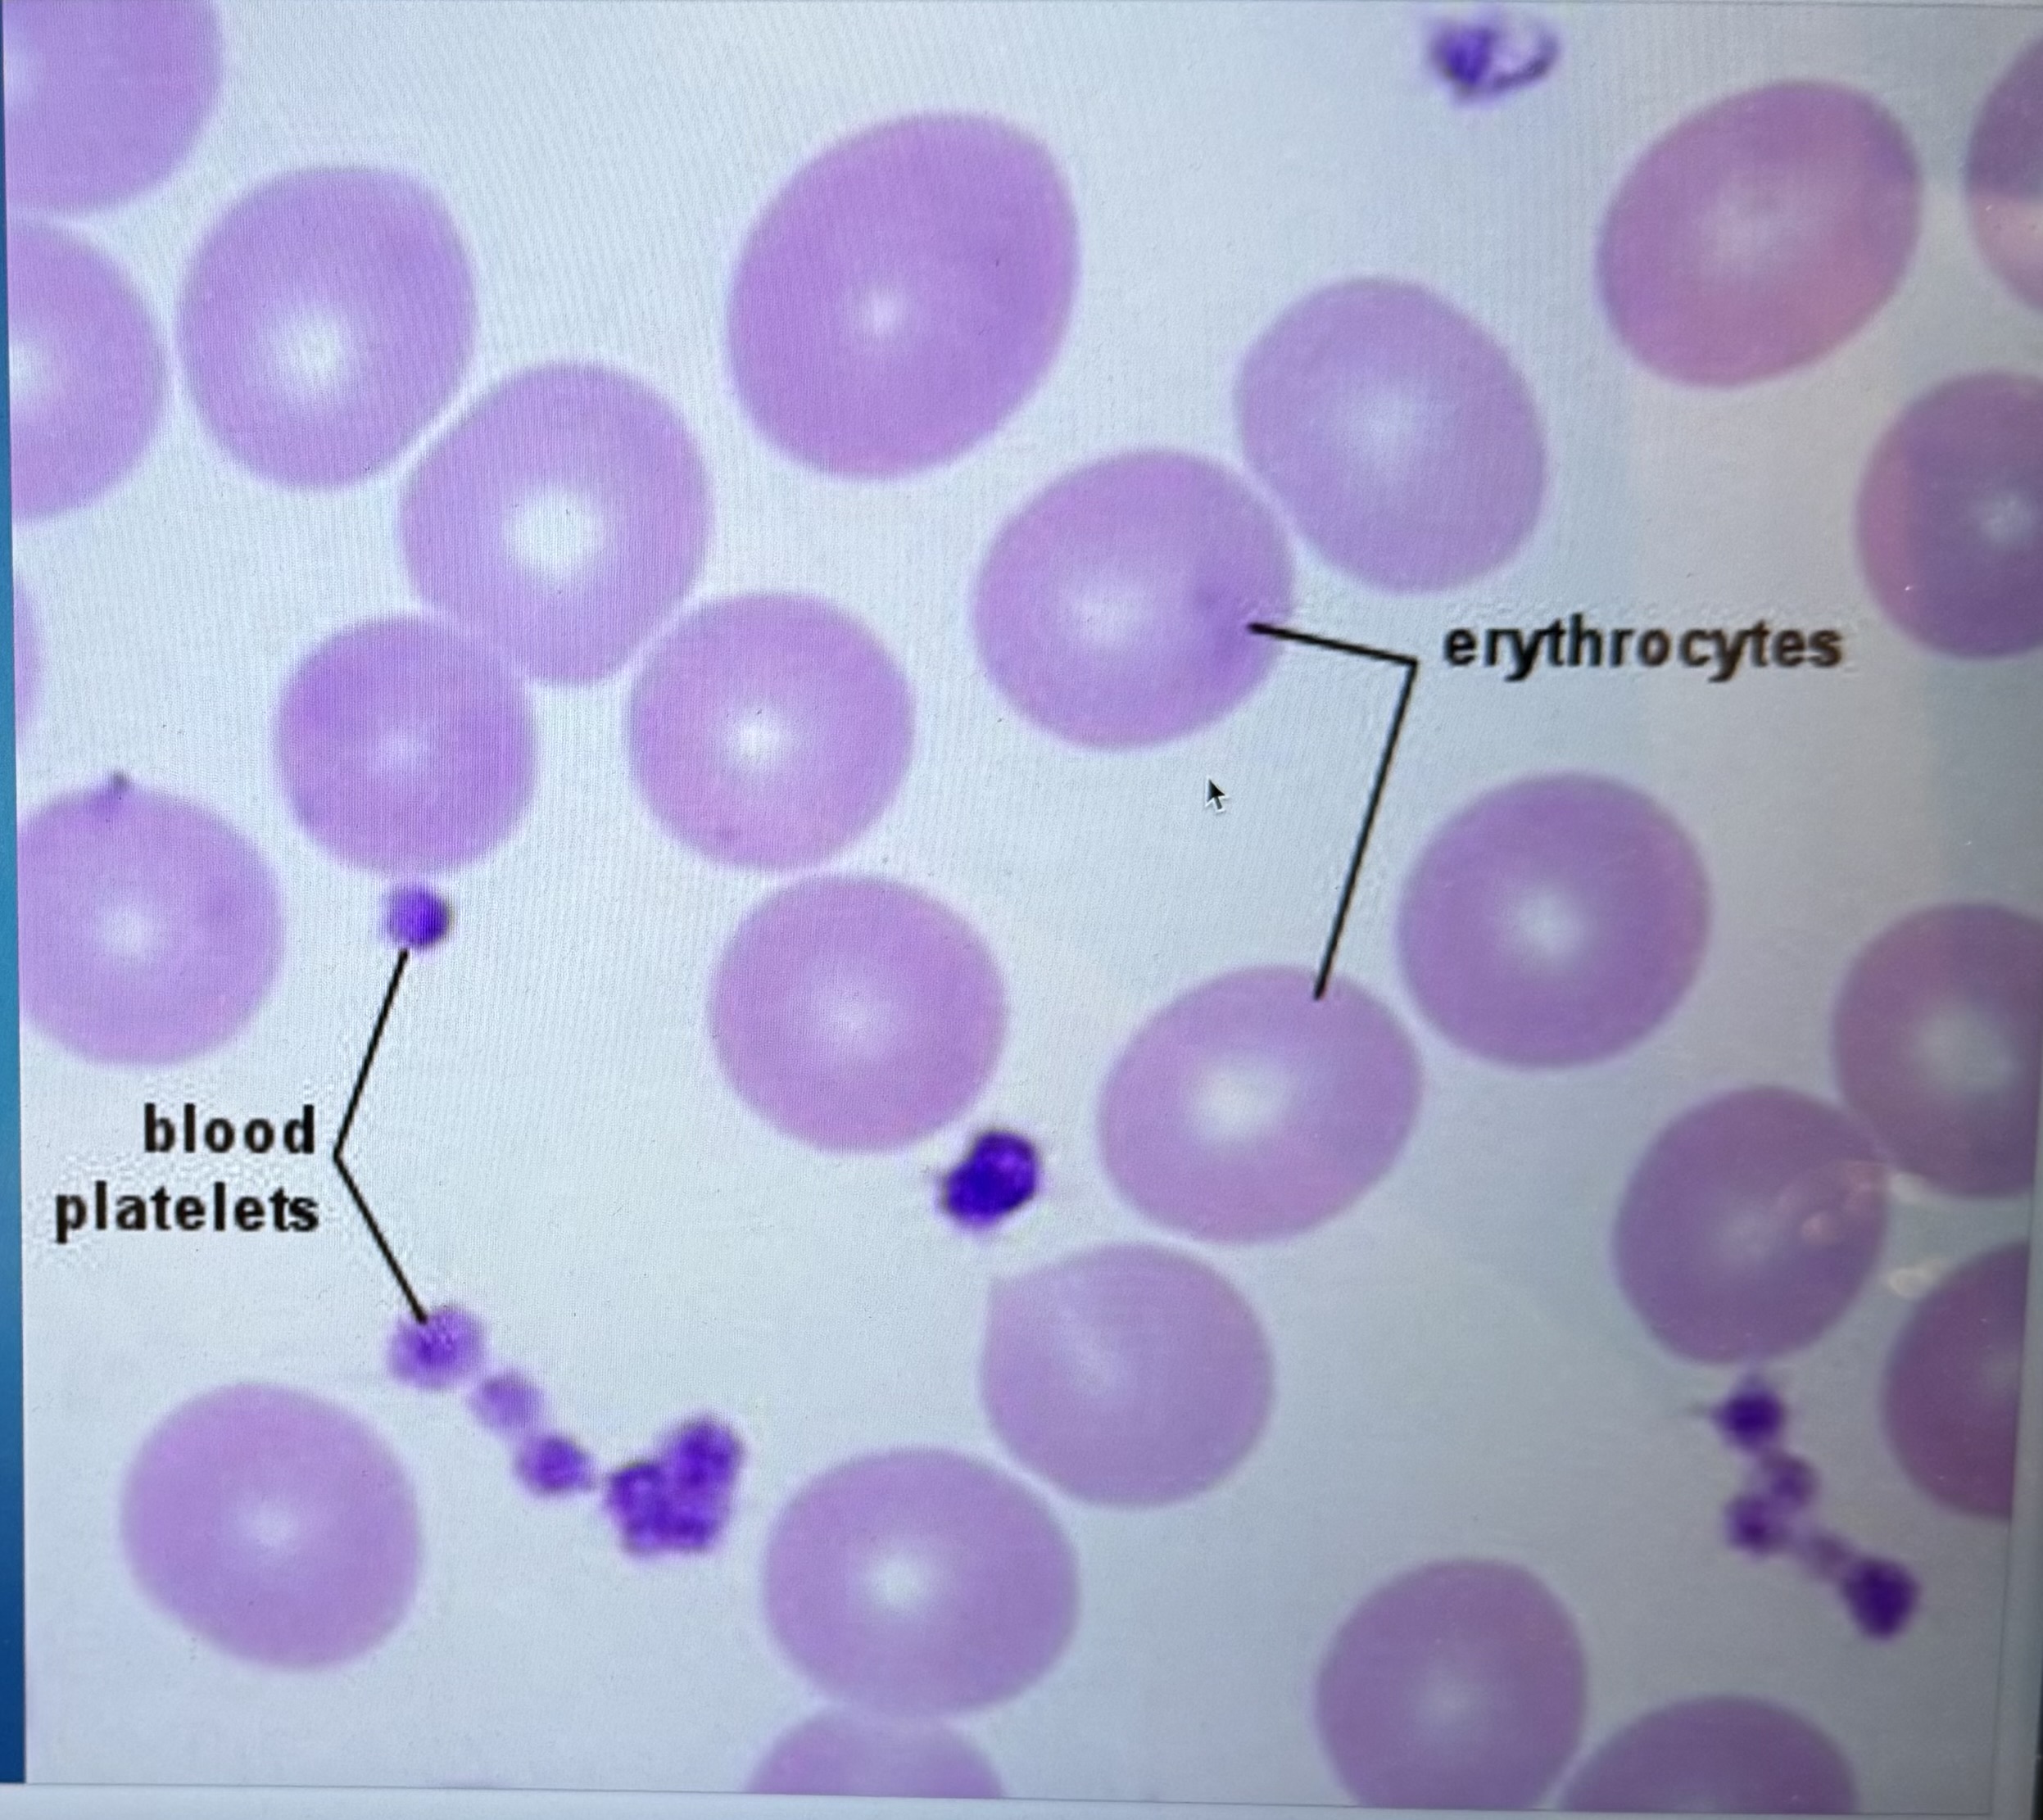
term image
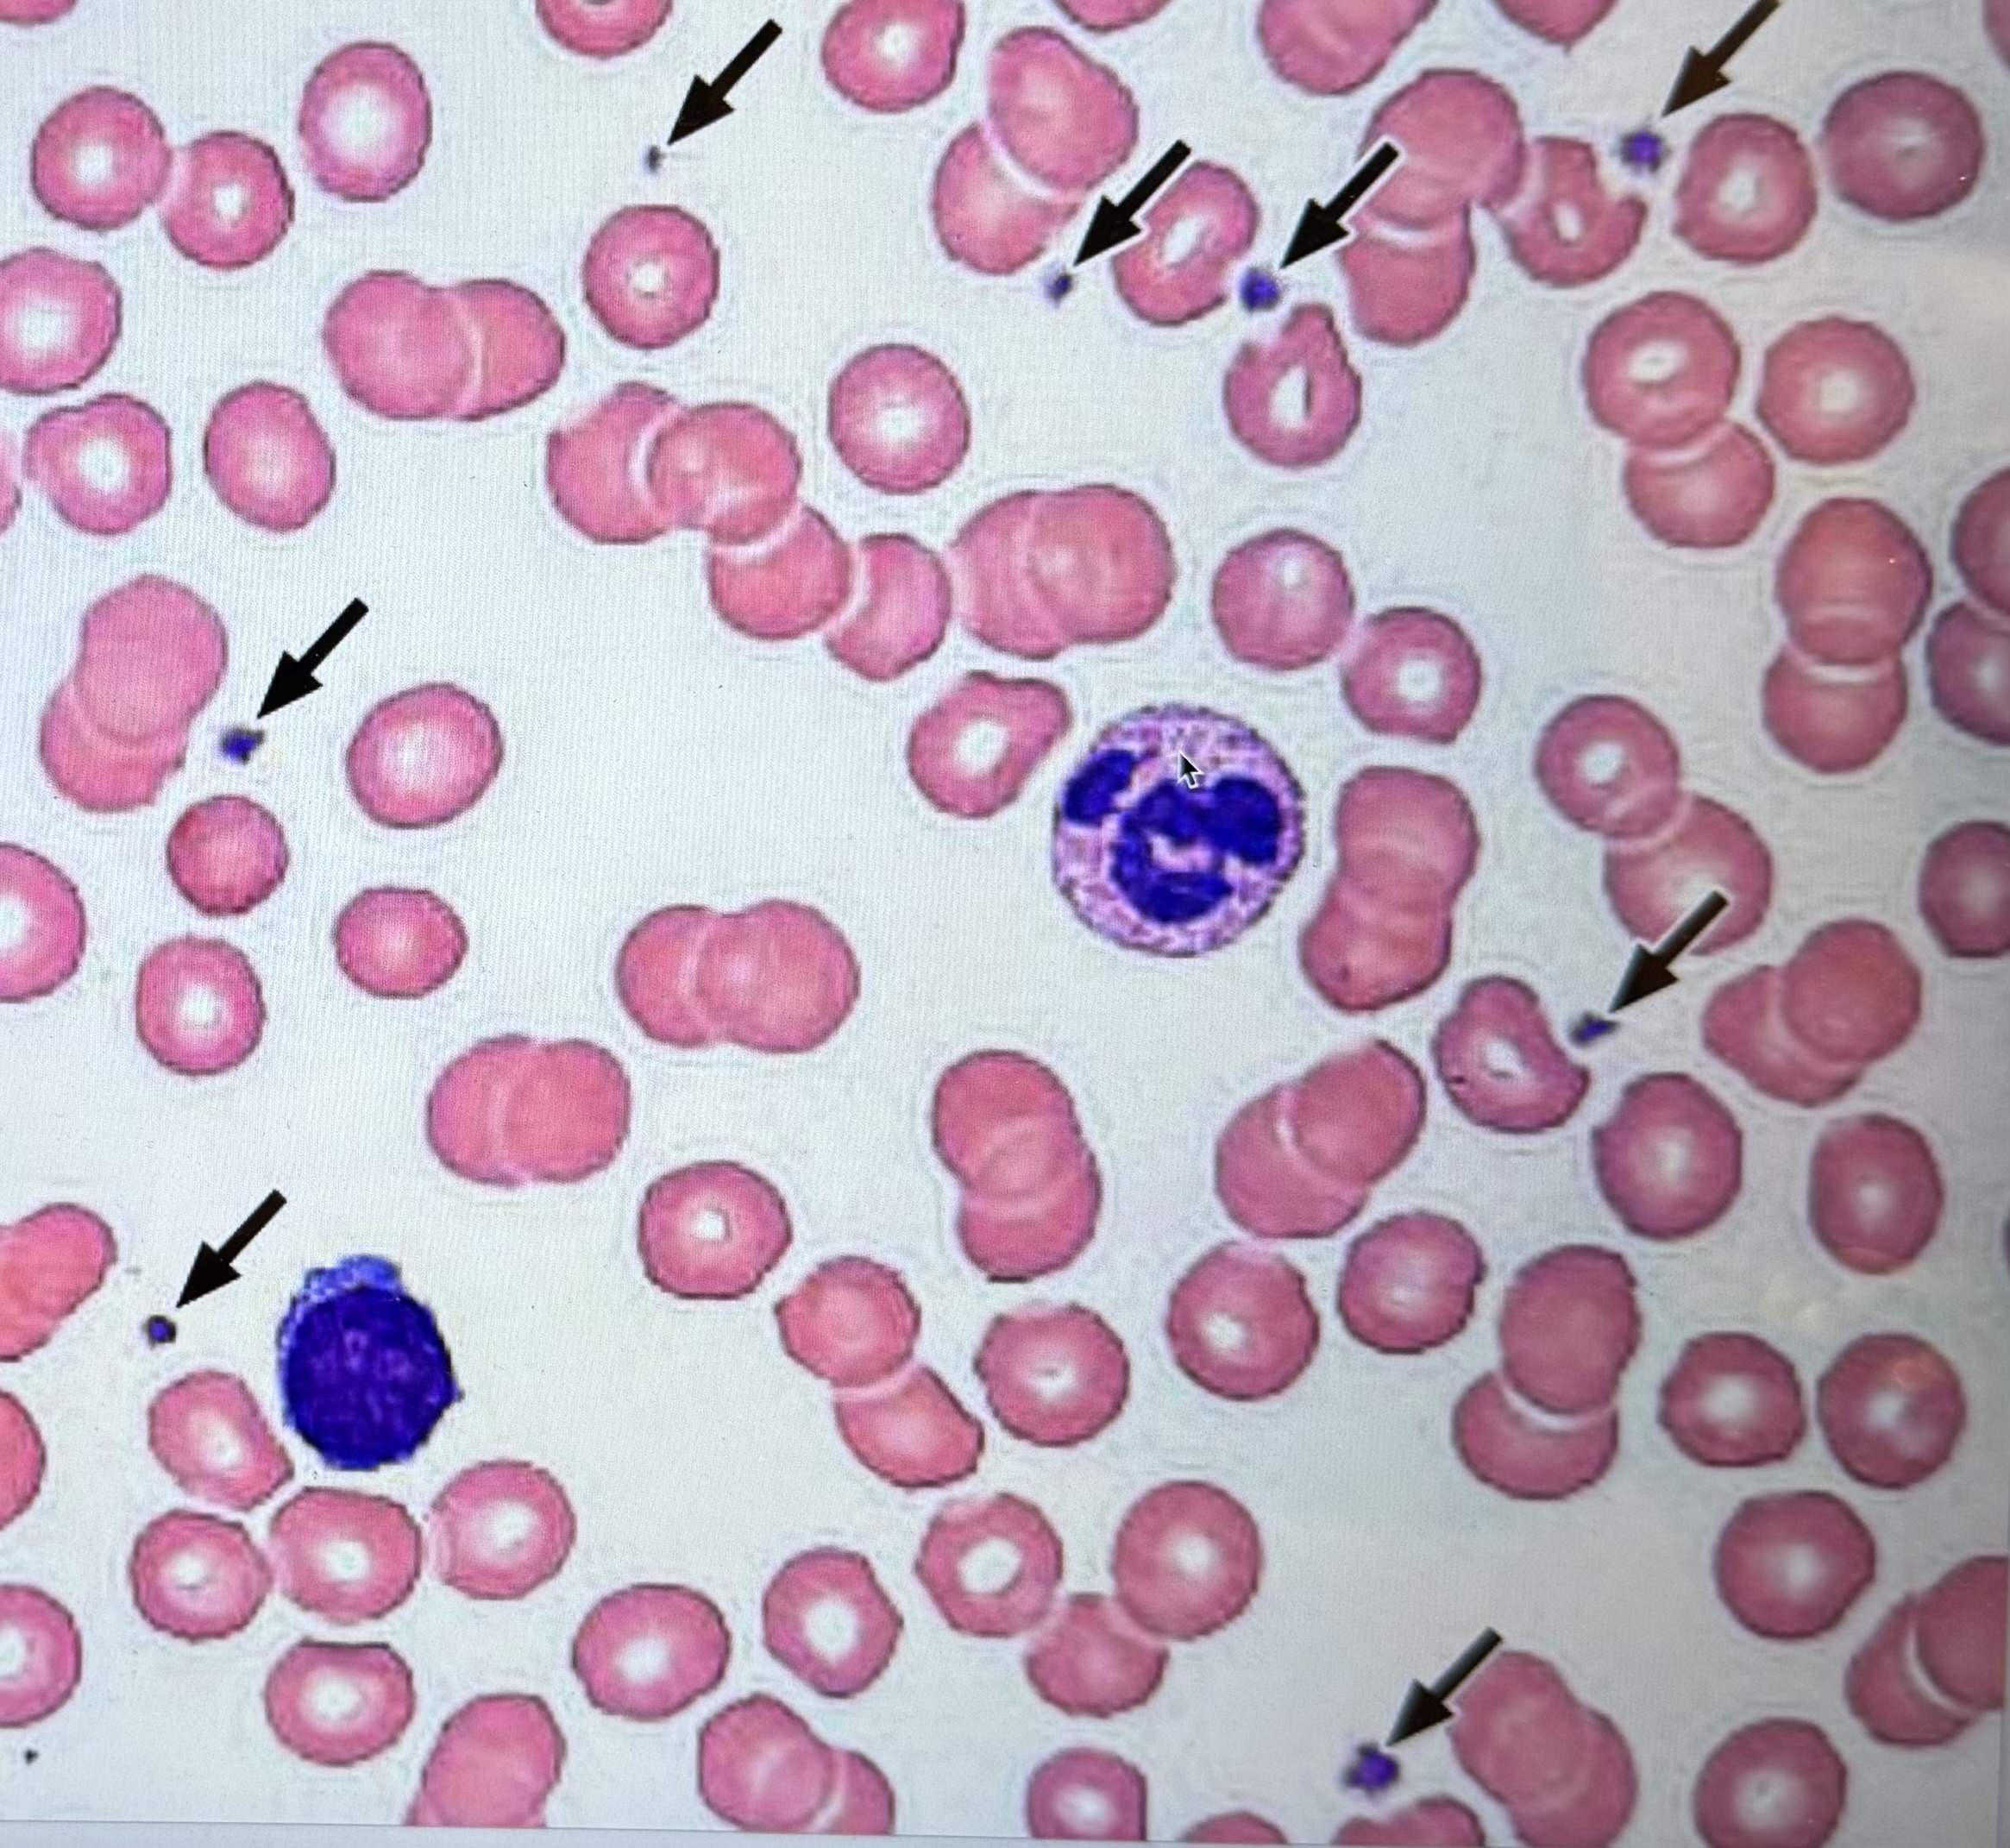
term image
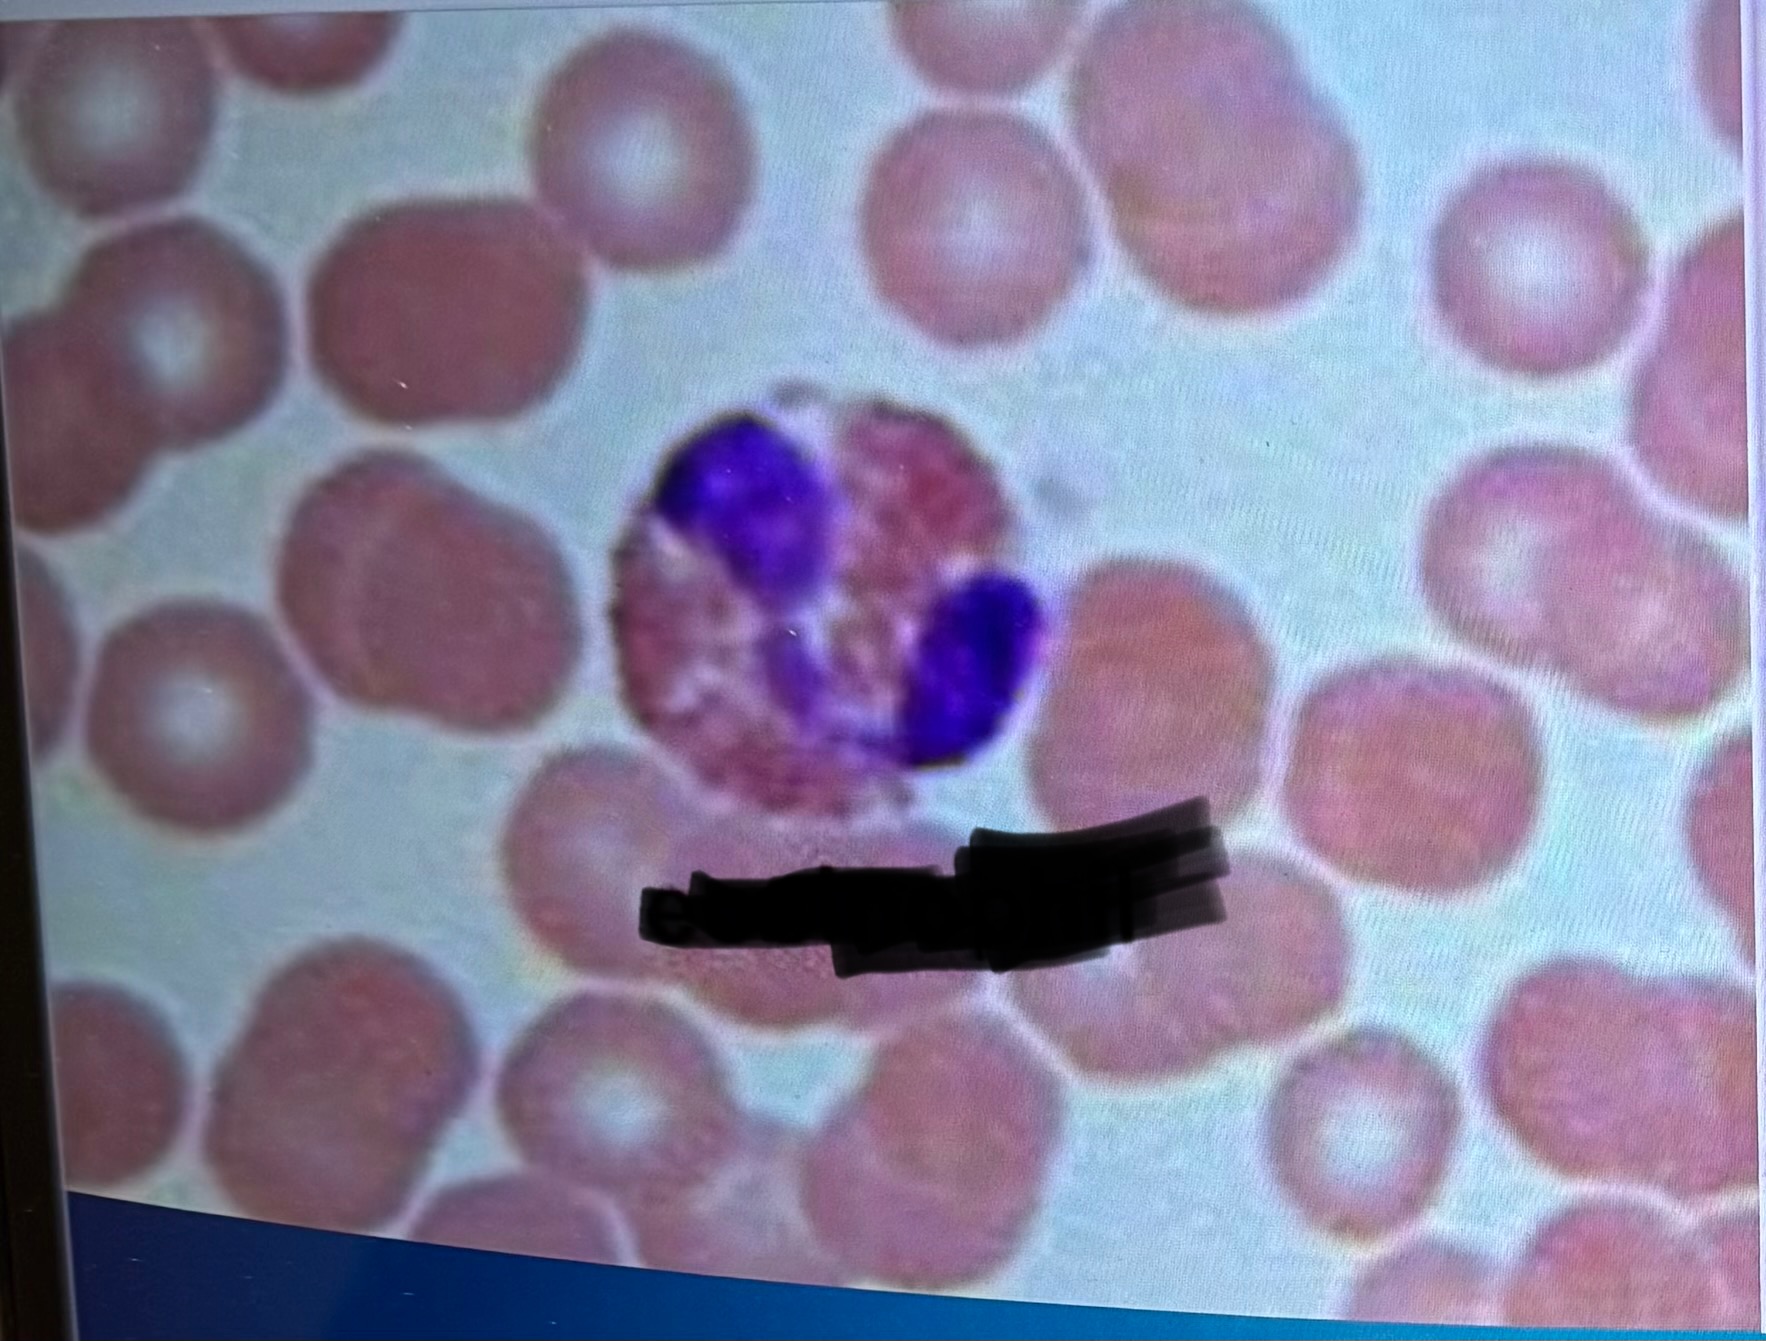
term image
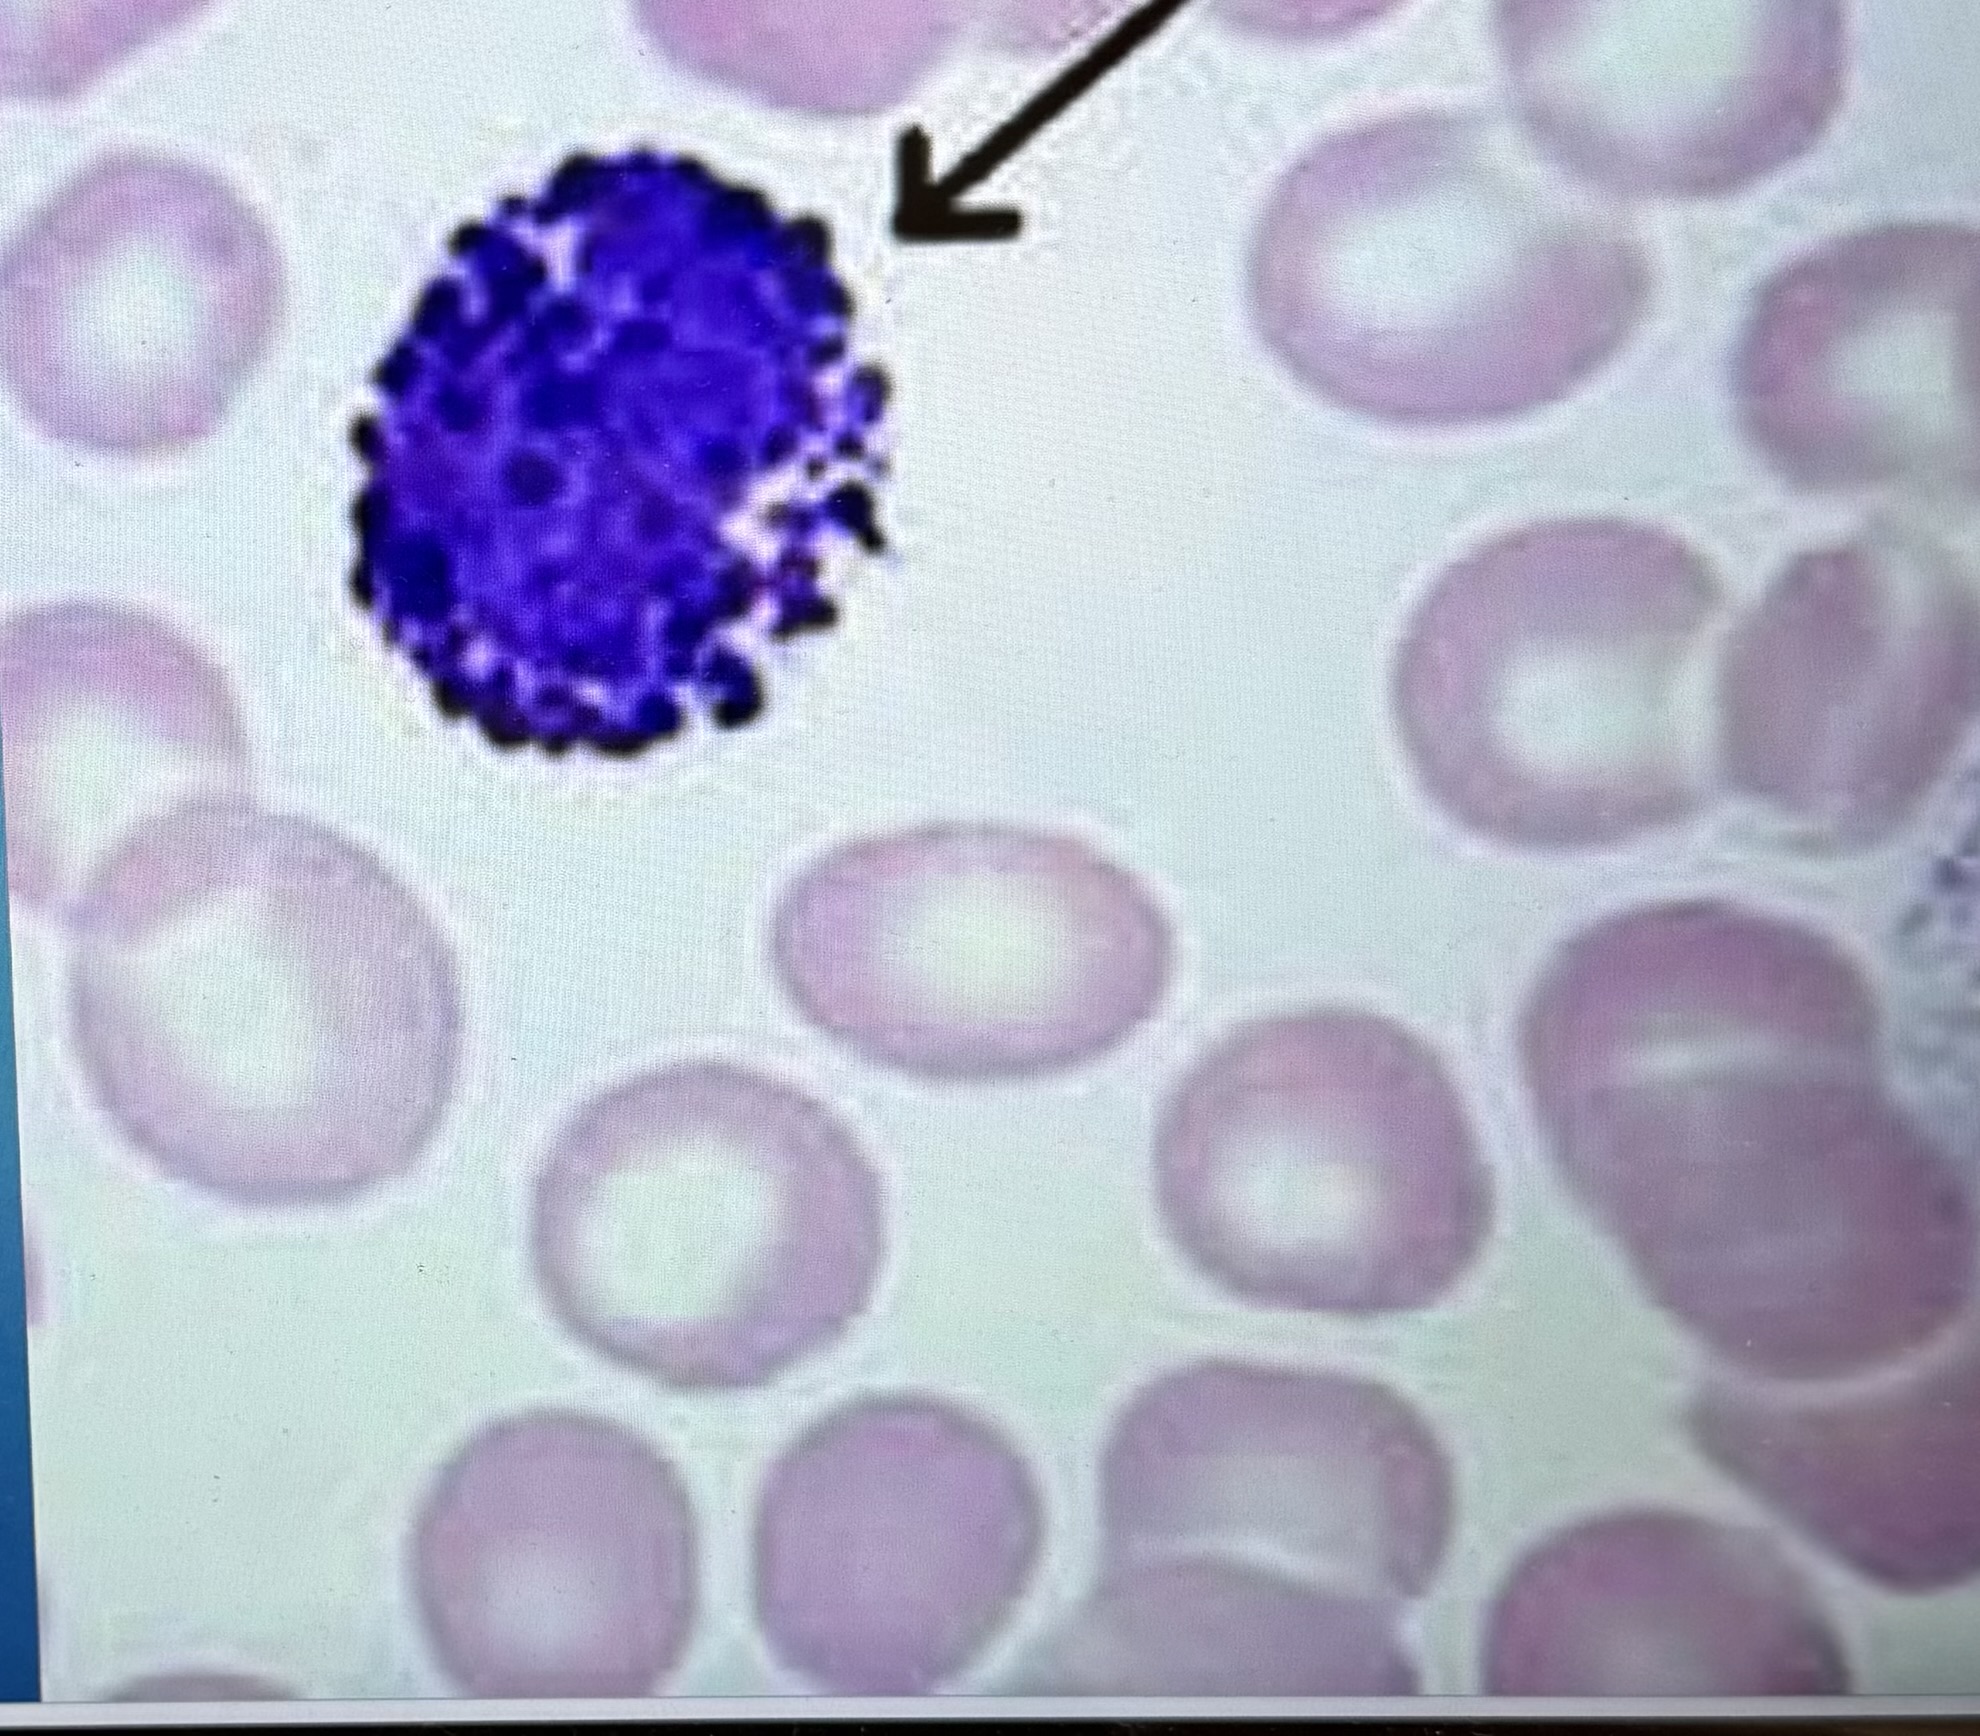
term image
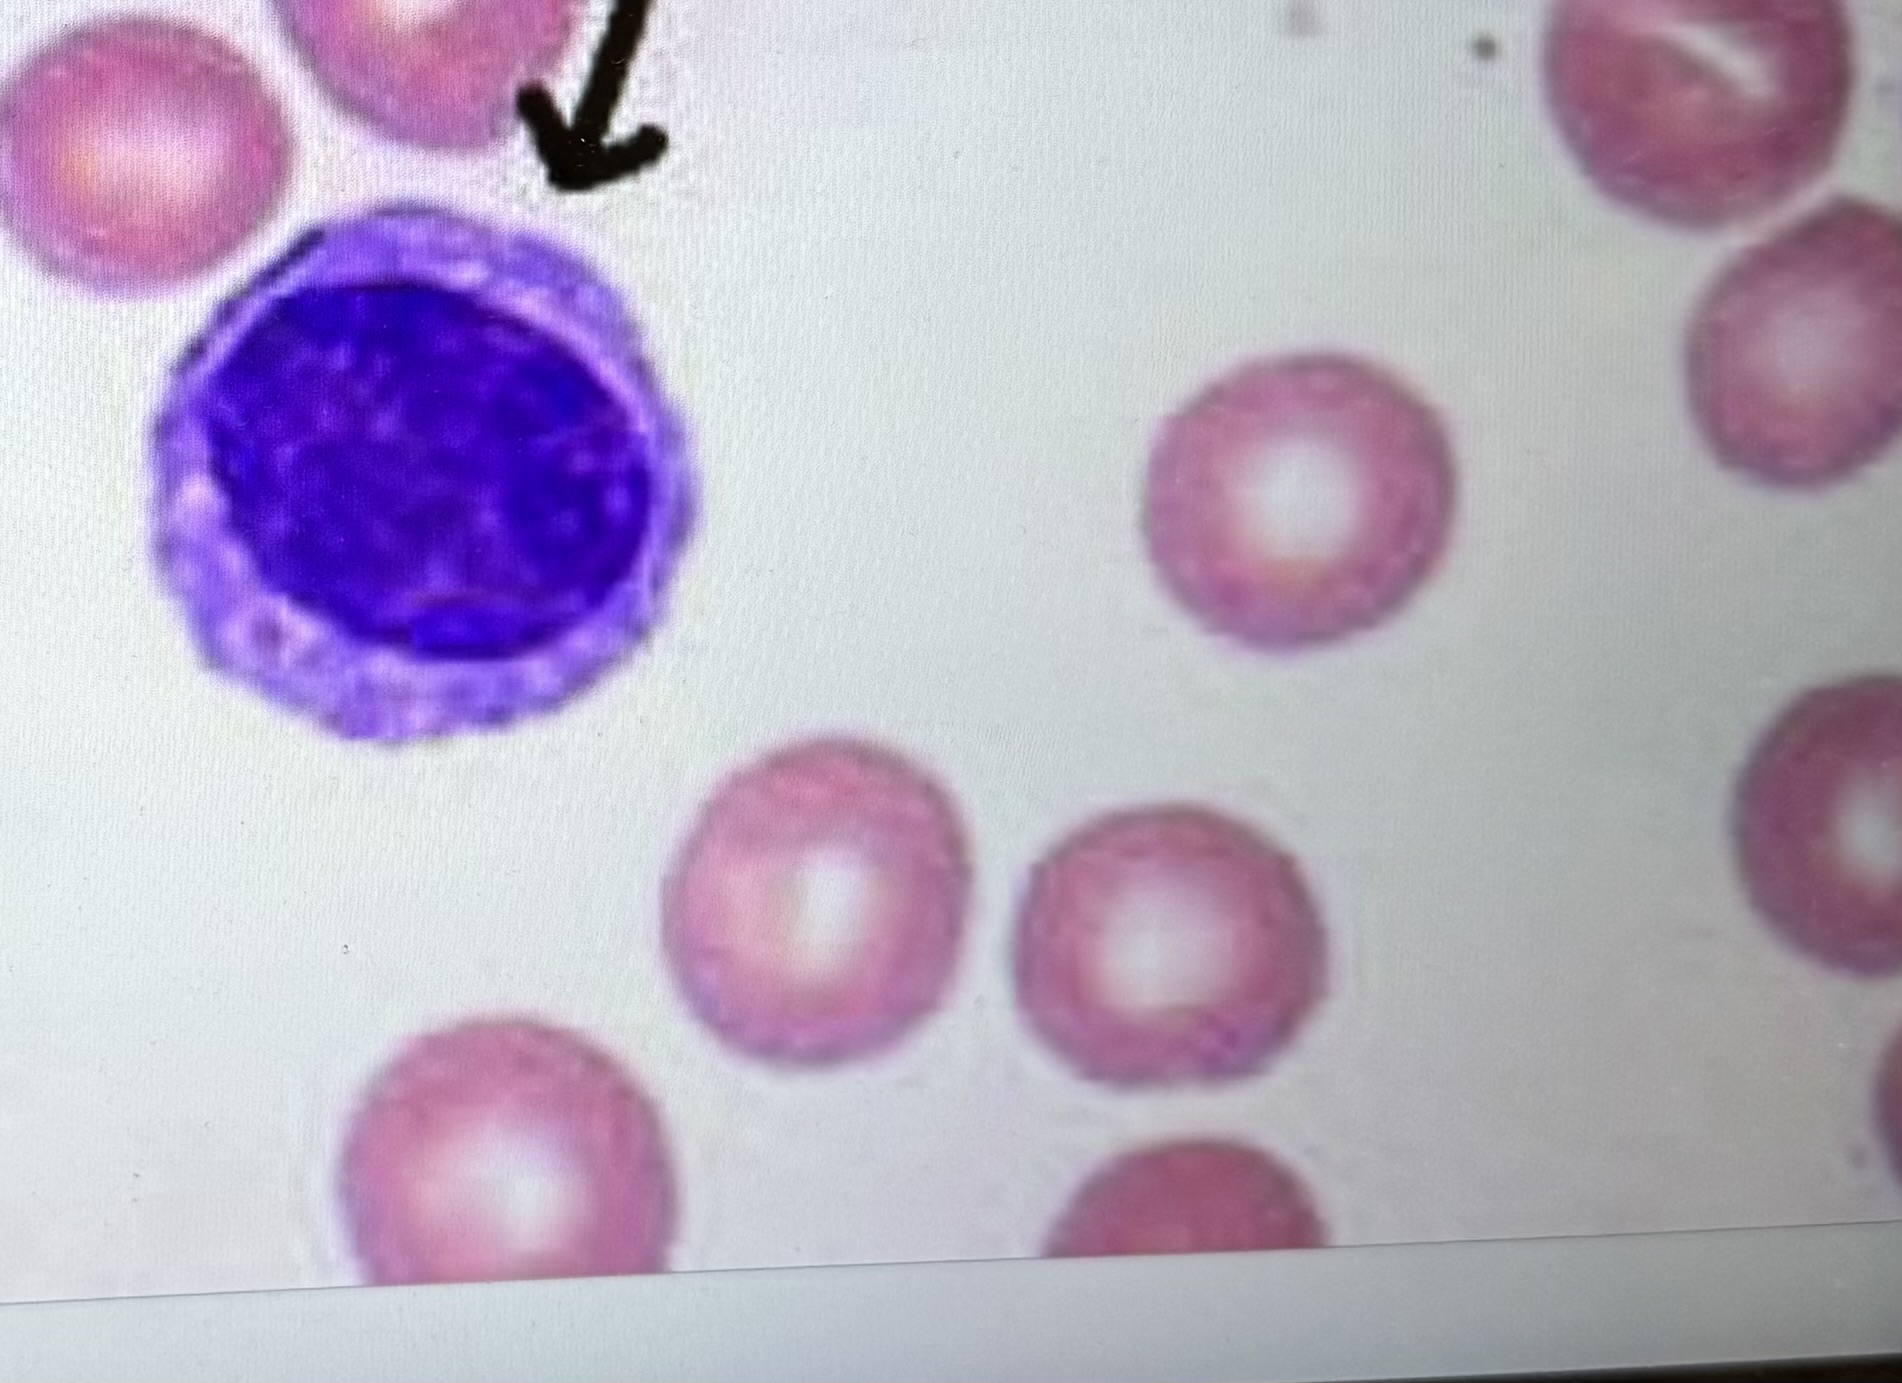
term image

Histology for lab exam 3
1/82
There's no tags or description
Looks like no tags are added yet.
Name | Mastery | Learn | Test | Matching | Spaced |
|---|
No study sessions yet.
83 Terms
Erythrocytes
Erythrocytes
Platelets

Neutrophils

Neutrophils
Eosinophils

Eosinophils
Basophils

Lymphocytes
Lymphocytes

Monocytes

Monocytes

Elastic artery

Muscular artery

Artery

Artery

Vein

Vein

Terminal Bronchiole

Respiratory Bronchioles

Alveolar Sac

Alveolar Duct

Alveoli

A.Terminal bronchiole

B.Respiratory bronchiole

C. Alveolar sac

D. Alveolar duct

Lympn Node

Mucosa

Submucosa

Muscularis Externa

Mucosa

Submucosa

1
Inner Circular Muscle

2
Outer Longitudinal Muscle

Digestive Tract Wall

Histology of the Stomach

1
Gastric pits

2
Mucosa

3
Submucosa

Histology of the Stomach

1
Lumen

2
Mucosa

3
Submucosa

4
Muscularis externa

1
Mucosa

2
Submucosa

3
Muscularis propria

4
Serosa

5
Inner oblique

6
Middle circular

7
"Outer longitudinal

Plicae Circularis

Small Intestine

1
Duodenal Glands

2
Villi

Duodenum

Peyer's Patches of ilum

Duodenum

Jejunum

lleum

Colon

Colon

Parotid gland:

Parotid gland:

Submandibular gland:

Submandibular gland:

Sublingual gland:

Sublingual gland:

ParotidGland

Gastic pit

Kupffer cells:

1
liver lobules

2
central vein

3
portal area

4
portal vein

5
hepatic artery

6
bile duct

Liver

1
bile canaliculi

2
hepatocytes

Pancreas Acinar cell

Pancreas Acinus